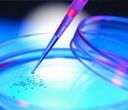
Una pipetta che distribuisce il liquido in una piastra di Petri con piccole colonie; toni blu e viola.

Articoli scientifici

Autore: ails_admin
•
14 giugno 2021
Articolo di J.A. Melo Gomes Reumatologo Pediatrico e Reumatologo, Lisbona, Portogallo. Qualsiasi malattia cronica è un grave problema per le persone che vengono colpite. Se questa malattia inizia prima che si sia raggiunta l’età adulta, questo problema sarà notevolmente accresciuto da tutte le ripercussioni che essa può avere sul processo di maturazione e sviluppo in […]
Autore: ails_admin
•
27 luglio 2018
Divulghiamo con piacere il Comunicato Stampa di uno studio appena pubblicato su Science Translational Medicine, da un gruppo di ricercatori dell’IRCCS Ospedale San Raffaele e dell’Università Vita-Salute San Raffaele, che hanno identificato il ruolo chiave di una singola molecola nello sviluppo della sclerodermia. Sclerodermia: identificata una molecola chiave nello sviluppo della malattia Milano, 26 luglio […]
Autore: ails_admin
•
25 gennaio 2018
Dr. Maurizio Gattinara – Reumatologia dell’Età evolutiva, ASST Gaetano Pini – CTO Milano La sclerodermia giovanile è un’identità clinica che può manifestarsi in età pediatrica con specifici aspetti sia clinici che epidemiologici. Le due principali forme sono la sclerosi sistemica progressiva e la sclerodermia localizzata. Le incidenze delle varie forme di sclerodermia sono sensibilmente […]
Autore: ails_admin
•
19 aprile 2017
Pubblicato a gennaio 2017 un importante studio clinico su Frontiers in Immunology, la rivista ufficiale dell’Unione Internazionale di tutte le Società Scientifiche d’Immunologia (IUIS), che accetta e pubblica solo le ricerche più rappresentative a livello mondiale. Tema dello studio: “Agonistic Anti-PDGF Receptor Autoantibodies from Patients with Systemic Sclerosis Impact Human Pulmonary Artery Smooth Muscle Cells […]
Autore: ails_admin
•
3 marzo 2017
Enrico Tombetti Medico Specialista in Allergologia ed Immunologia Clinica Ospedale San Raffaele Dottorando in Medicina Molecolare Università Vita-Salute San Raffaele Milano Per migliorare l’offerta ai pazienti con Sclerosi sistemica, l’Unità di Immunologia, Reumatologia, Allergologia e Malattie Rare dell’Ospedale San Raffaele ha deciso di potenziare il servizio ambulatoriale per i malati con Sclerosi sistemica, […]
Autore: ails_admin
•
6 dicembre 2016
Dott. Nicola Boffini Specialista in Reumatologia IRCCS Ospedale San Raffaele, Milano In questi ultimi anni l’indagine ecografica ha acquistato sempre più importanza all’interno della diagnostica delle patologie reumatologiche. In particolare le varie sfumature dell’ecografia articolare e muscolo-tendinea si sono ormai ampiamente inserite come elemento imprescindibile della valutazione globale del paziente reumatologico e quindi del bagaglio […]
Autore: ails_admin
•
2 dicembre 2016
In occasione del Congresso Nazionale della Società Italiana di Reumatologia ( Rimini, 23-26 novembre 2016), la comunicazione orale dal titolo “Bosentan and Macitentan reverse the endothelial to mesenchymal transition (EndoMT) in Systemic Sclerosis”, presentata dal dott. Claudio Corallo, afferente alla Scleroderma Unit dell’Azienda Ospedaliera Universitaria Senese, è stata scelta e premiata tra le comunicazioni orali […]
Autore: ails_admin
•
14 luglio 2016
Vista la possibilità d’insorgenza in donne giovani in età fertile, non si può non considerare l’impatto della malattia sulla pianificazione familiare e il desiderio di maternità della donna...







